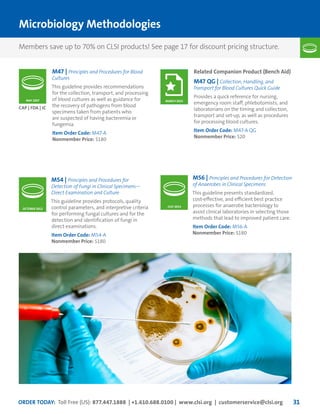
ORDER TODAY: Toll Free (US): 877.447.1888 | +1.610.688.0100 | www.clsi.org | customerservice@clsi.org 31
Microbiology Methodologies
M47 | Principles and Procedures for Blood
Cultures
This guideline provides recommendations
for the collection, transport, and processing
of blood cultures as well as guidance for
the recovery of pathogens from blood
specimens taken from patients who
are suspected of having bacteremia or
fungemia.
Item Order Code: M47-A
Nonmember Price: $180
M54 | Principles and Procedures for
Detection of Fungi in Clinical Specimens—
Direct Examination and Culture
This guideline provides protocols, quality
control parameters, and interpretive criteria
for performing fungal cultures and for the
detection and identification of fungi in
direct examinations.
Item Order Code: M54-A
Nonmember Price: $180
CAP | FDA | JC
M56 | Principles and Procedures for Detection
of Anaerobes in Clinical Specimens
This guideline presents standardized,
cost-effective, and efficient best practice
processes for anaerobe bacteriology to
assist clinical laboratories in selecting those
methods that lead to improved patient care.
Item Order Code: M56-A
Nonmember Price: $180
JULY 2014
MAY 2007
OCTOBER 2012
Related Companion Product (Bench Aid)
M47 QG | Collection, Handling, and
Transport for Blood Cultures Quick Guide
Provides a quick reference for nursing,
emergency room staff, phlebotomists, and
laboratorians on the timing and collection,
transport and set-up, as well as procedures
for processing blood cultures.
Item Order Code: M47-A QG
Nonmember Price: $20
MARCH 2015
Members save up to 70% on CLSI products! See page 17 for discount pricing structure.

This document provides information about joining CLSI (Clinical and Laboratory Standards Institute) membership. Membership offers benefits like discounts on CLSI standards and programs, opportunities to collaborate on standards development, and continuing education credits. There are different levels of membership for laboratories, health systems, industries, government agencies, and individuals. Membership helps laboratories improve quality through implementing CLSI standards.